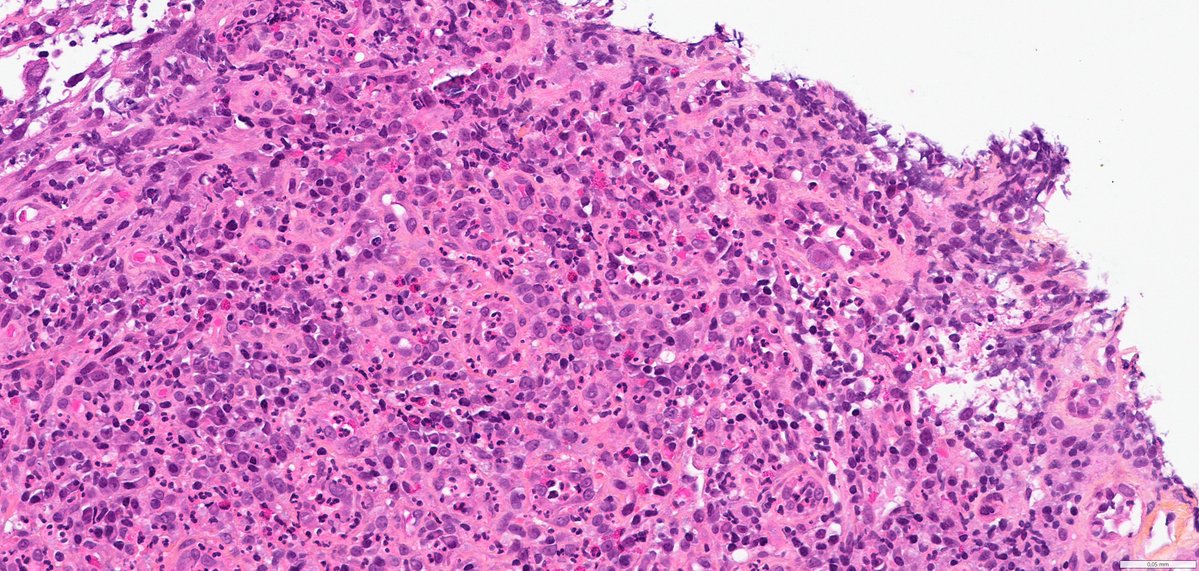
Ana-Maria Catana tweet media
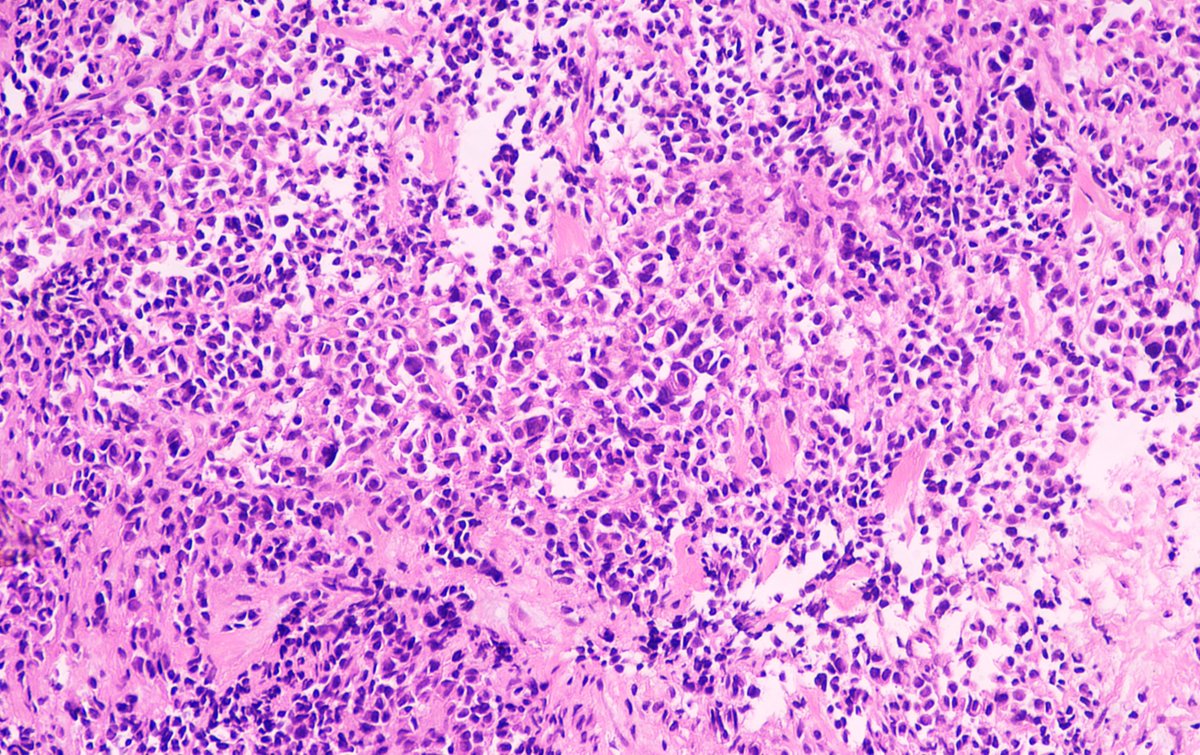
Sumanta Das tweet media

Meryem Terzioglu, MD retweetledi

Pseudocarcinomatous urothelial hyperplasia (PCUH):
• Florid nests/cords of urothelium, mimic invasion
• Vascular injury, hemorrhage ± fibrin thrombi
Seen in:
• Prior pelvic radiation
• Ischemic injury
👉 Not a neoplasm — but a classic mimic.
pubmed.ncbi.nlm.nih.gov/23228381/
Guannan Zhang ,张冠楠,MD, PhD@GuannanTiffany
🧩 Bloody Bladder When signing out this lesion, what clinical question comes to mind? 👨 65-year-old man • Prior prostate adenocarcinoma? 👩 45-year-old woman • Prior cervical carcinoma? not always. So… what’s the diagnosis? 🤔 #DxMindMap #BladderTumor #PathTwitter #JHUPath
English